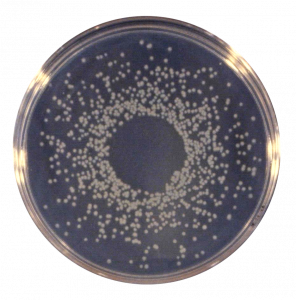
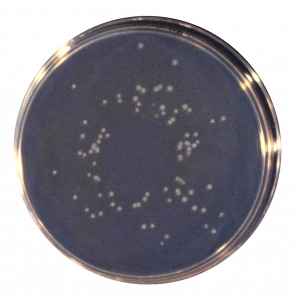

Introducing Flornano
Flornano is a Singapore brand with a strong sense of social responsibility. Based on nature and modern science and technology, it is close to natural ecology to improve human settlements. Working closely with European and Asian cross-border technology research and development scientists, we are developing healthy, convenient, low-carbon, fashionable and environmentally friendly high-tech innovative building materials.
Hygienic blind angle


In daily life, it is not difficult to find that
Room air-cleaning


How FLORNANO Works
Inspired by nature, we simulate the power of nature and create a new type of sterile floor. Let our living space be closer to hygienic, clean and refreshing nature.
- Just need sunlight or indoor light, Energize Nano TiO2 Particles on floorbaord surface, Highly reactive TiO2 electron aggresively combines with pollutants (germs, bacteria, VOCs).
- Pollutant effectively oxidised (burned), Broken into harmless H2O & CO2 ions making indoor air cleaner and hygienic.
FLORNANO ‘s solution

Disinfection and Sterilization

Purifying VOC (Formaldehyde, etc..)
TIO2 electron not only removes bad odour but also purifies harmful VOC and thus improving indoor air quality(IAQ).

Deodorising Effect
The highly reactive TIO2 electrons are release into the air decompose pollutants that let bad odour into odourless hygienic(clean)air.

Release Negative Ions

Indefinite Lifespan
The properties of Nano tio2 can never be consumed, therefore lifespan of Nano TiO2 is infinite. 24/7 Self-Sustaining (Work relentlessly in a self –sustaining ways as long as there is a lighting source(a.k.a Photocatalysis process).

Authoritative Testing and Authentication
Floor without Flornano Technology
Over time, bacteria grow very quickly.
Floor with Flornano Technology
The effect of killing bacteria and inhibiting bacterial growth is very obvious.

PSB Singapore
TÜV SÜD PSB is accredited under the Singapore Accreditation Council Singapore Laboratory Accreditation (SAC-Singlas) Scheme to ISO/IEC Guide 25 (ISO/IEC 17025) and ISO Guide 65 (ISO/IEC 17065).


